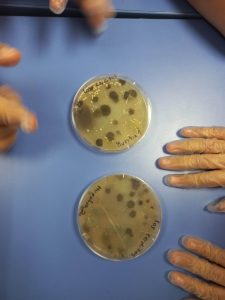
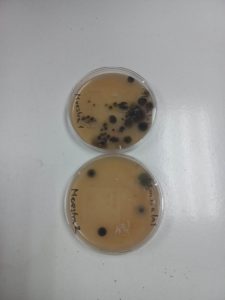

Durante las semanas recientes, los estudiantes del 5° A y B, trabajaron en la realización de cultivos de microorganismos durante las clases de Ciencias Naturales con la Profesora Camila Pérez. Esta actividad refuerza habilidades científicas como la observación, planteamiento de hipótesis, experimentación, descripción y análisis, además de permitirles reflexionar sobre el entorno que los rodea y la importancia de la higiene diaria.